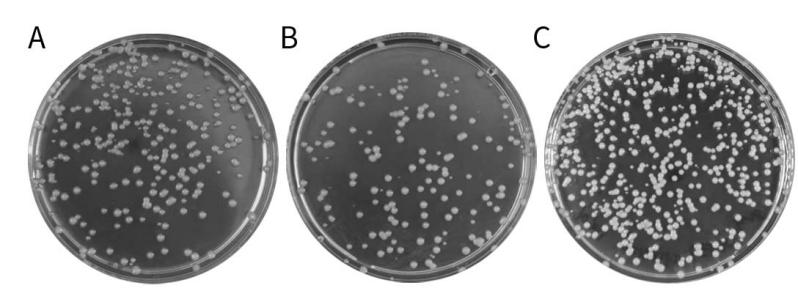
产品细节图片1

相关产品推荐更多 >
万千商家帮你免费找货
0 人在求购买到急需产品
- 详细信息
- 文献和实验
- 技术资料
- 库存:
现货
- 保质期:
一年
- 供应商:
上海经科化学科技有限公司
- 保存条件:
-20℃
- 规格:
100次
产品简介:
碧云天生产的农杆菌感受态制备试剂盒(Agrobacterium Competent Cells Preparation Kit),是一种专门用于农杆菌感受态快速制备的试剂盒。农杆菌经过本试剂盒处理后,细胞膜的通透性发生了暂时性的改变,成为能允许外源DNA分子进入的感受态细胞。
农杆菌常生活在植物根表面,依靠由根组织渗透出来的营养物质生存,是一类广泛存在于土壤中的革兰氏阴性细菌,常用于基因过表达、敲除、敲减和编辑等转基因植物的构建。根瘤农杆菌Ti质粒上的T-DNA上有8个左右的基因在植物细胞内表达,指导合成一种特殊化合物冠瘿碱,引起转化细胞癌变;而发根农杆菌的Ri质粒同样含有T-DNA,可诱导产生发状根,其特征是大量增生高度分支的根系。
本试剂盒适用于绝大多数常见的农杆菌,如GV3101、EHA101、LBA4404和EHA105等根瘤农杆菌(Agrobacterium tumefaciens)或C58C1和Ar.1193等发根农杆菌(Agrobacterium rhizogenes)感受态细胞的制备。使用本试剂盒可以使感受态转化效率达到103-104cfu/μg质粒。但是不同种类农杆菌菌种制备出来的感受态细胞,转化效率可能有较大差异。此外,对于较小的质粒转化效率会略高,而对于较大的质粒则转化效率会略低一些。
本试剂盒操作简单,细菌培养后仅需1个小时左右即可完成感受态细胞的制备。
本试剂盒提供了专门用于制备农杆菌感受态的培养液,使感受态的制备更加便捷。
使用碧云天生产的农杆菌感受态制备试剂盒制备的农杆菌感受态转化效果参考图1。
图1. 使用碧云天农杆菌感受态制备试剂盒制备的农杆菌感受态转化效果图。使用本试剂盒制备的感受态在液氮中速冻后保存在-80℃。取-80℃保存的农杆菌感受态放置于室温片刻,待其部分融化,处于冰水混合状态时插入冰浴中。每100 μl感受态细胞加入0.1μg质粒DNA,用手拨打管底混匀,依次于冰上静置15min、液氮1-3min、37℃水浴3-5min。 然后在超净台中加入500 μl无抗生素的LB或YEB液体培养基,28℃振荡培养2h。4000×g离心1min收菌,留取100 μl左右上清轻轻吹打重悬农杆菌沉淀,涂布于含相应抗生素的LB或YEB平板上,倒置放于28-30℃培养箱培养2-3天。GV3101转化效果见图1A(转化效率约为3×103 CFU/μg质粒),LBA4404转化效果见图1B(转化效率约为1.5×103 CFU/μg质粒),EHA101转化效果见图1C(1×104 CFU/μg质粒)。本产品的实际使用效果会因具体实验条件、实验材料等的不同而存在差异,图中效果仅供参考。
本试剂盒可以分多次使用,共可以制备足够进行100次转化的感受态细胞。
保存条件:
-20℃保存,一年有效。 利福平须避光保存。
注意事项:
本试剂盒中提供的利福平溶液如果出现沉淀,属于正常现象,可以在充分溶解后使用。
感受态制备的过程中须注意无菌操作,避免其它微生物的污染。
本产品仅限于专业人员的科学研究用,不得用于临床诊断或治疗,不得用于食品或药品,不得存放于普通住宅内。
为了您的安全和健康,请穿实验服并戴一次性手套操作。
风险提示:丁香通仅作为第三方平台,为商家信息发布提供平台空间。用户咨询产品时请注意保护个人信息及财产安全,合理判断,谨慎选购商品,商家和用户对交易行为负责。对于医疗器械类产品,请先查证核实企业经营资质和医疗器械产品注册证情况。
文献和实验双元载体的农杆菌转化1.1农杆菌感受态细胞的制备1.1.1. 取-70℃保存的EHA105于含50μg/ml链霉素平板划线,28℃培养。1.1.2. 挑取单菌落接种于5ml YM液体培养基中,220rpm 28℃振荡培养12-16 hr。1.1.3. 取2ml菌液转接于100ml YM液体培养基中,28℃220rpm振荡培养至OD600=0.5。1.1.4. 转入无菌离心管,5000rpm离心5min,去上清液。1.1.5. 加入10ml预冷的0.1M的CaCl2溶液,轻轻悬浮细胞,冰上放置
相关专题 DNA连接与转化 农杆菌感受态细胞的制备 1.挑取少许农杆菌LBA4404,接种于5ml LB液体培养基 (含50mg/L STR)中,28℃、200r/mim培养过夜。 2.取2ml培养物于LB液体培养基 (含50mg/L STR) 中继续培养,直至OD800 为0.5左右。 3.将培养物置冰浴中30min,4℃、5000r/min、离心5min,弃去上清液。 4.用10ml冷
The Inoue Method for Preparation and Transformation of Competent E. coli: "Ultra Competent" Cells Joseph Sambrook Peter Maccallum Cancer Institute and The University of Melbourne
技术资料暂无技术资料 索取技术资料









